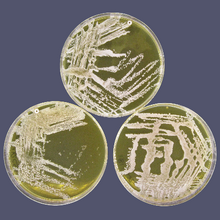
Quadram press release thumb.png

Tracking the bacteria behind life-threatening sepsis in premature babies
04 October 2023
A new study from the Quadram Institute and University of East Anglia into sepsis in neonatal babies has uncovered the secrets of the bacteria’s success in causing this life-threatening condition.
Using genomic sequencing, they have found how certain strains of bacteria that usually live harmlessly on the skin can evade control measures by colonising babies’ guts. This will provide new ways to control this threat to babies’ health.
Premature babies in neonatal care units are extremely vulnerable, and susceptible to life-threatening infections. To help keep these babies safe the risk of infection needs to be kept as low as possible.
A particular problem is late onset sepsis that starts from three days after birth, when bacteria get into the blood and grow. This can be very dangerous and babies with late onset sepsis end up staying in hospital longer, need more treatment with antibiotics and can be left with life-long effects on their health.
Bacteria from the Staphylococcus family are the most common causes of late onset sepsis. Most members of this large group of bacteria are harmless; they are normal colonisers of our skin, which can even protect us from harmful microbes. However, some strains, when they end up in the wrong place and get inside the body, can cause major problems, particularly for immunocompromised individuals like neonatal babies.
Staphylococcus capitis is an example of this. This is a species which is usually content living on our scalp, face and neck; capitis means “of the head’ in Latin. Some strains of S. capitis are however associated with late onset sepsis. One particular strain, known as NRCS-A, has been identified as causing serious infections in neonates around the world.
Scientists think this strain first emerged in the 1960s and spread globally throughout the 1980s as it evolved resistance to the commonly used antibiotic vancomycin. Strains circulating now show resistance to multiple antibiotics and a reduced susceptibility to antiseptics that we use to sterilise the skin of babies. This makes the bacteria harder to treat and control, but exactly why this NRCS-A strain has become so globally successful has remained a mystery.
To try and understand what makes this strain able to spread around the world and to develop better ways to keep it under control, Professor Mark Webber and his team from the Quadram Institute and University of East Anglia analysed the genomes of hundreds of S. capitis isolates. They worked with two Neonatal Intensive Care Units (NICUs), one in the UK and one in Germany, obtaining samples of S. capitis from the skin and gut of neonatal babies, with and without late onset sepsis.
Their results, published in the journal Microbial Genomics, found that the NRCS-A strain was commonly carried on the skin and in the gut of uninfected neonatal babies, that transmission between babies within NICUs was likely.
By reading the complete genome of each sample, the team were able to identify tiny genetic differences between the S. capitis strains that caused disease and those that don’t.
Professor Webber and his team found that the NRCS-A strains that can cause disease carried a set of unique genes, which they think allows them to survive in the gut as well as on the skin. This would make cleaning the skin to eradicate the bacteria ineffective as the babies will carry a reservoir in their gut microbiomes that cannot be easily removed, but can act as a source of infection.
The genes found in the NRCS-A strains allow them to be resistant to nisin, an antimicrobial compound naturally produced by bacteria in the gut. They also carried genes to survive exposure to the toxic metals that our immune system uses to kill bacteria, as well as genes to scavenge essential metals that are known to be hard for bacteria to access in the gut environment.
Further experiments also showed that the bacteria grow better in acidic conditions as found in the gut. Together, the evidence supports the idea these bacteria are adapted to exploit growth in the gut.
If metal scavenging is critical to infection, this may also be the bacteria’s Achilles heel, presenting a new way to counter its threat. There is early evidence that feeding babies a probiotic supplement of benign bacteria reduces the rate of late onset sepsis and that these ‘good bacteria’ can extract metals before the S. capitis, preventing their growth.
“Studying how strains like NRCS-A have become globally successful is crucial to understanding how bacteria evolve to colonise different environments, and to give us new ideas about how to reduce the risks of infection in vulnerable populations” said Professor Webber.
“We hope this work can be the starting point for more research to develop better ways to protect newborn babies from the terrible consequences of infection.”
Dr Heather Felgate from the Quadram Institute and lead author on the study said “There are still many questions to answer as to why NRCS-A has become so globally spread amongst NICU. But, working out how NRCS-A can evade the host immune system, spread and survive can also give us a head start with many other Staphylococcal species that cause sepsis in immunocompromised people in NICU and Intensive care units.”
NOTES FOR EDITORS:
The full paper ‘Characterisation of neonatal Staphylococcus capitis NRCS-A isolates compared with non NRCS-A Staphylococcus capitis from neonates and adults’ by Heather Felgate, Dheeraj Sethi Kirsten Faust, Cemsid Kiy, Christoph Härtel, Jan Rupp, Rebecca Clifford, Rachael Dean, Catherine Tremlett, John Wain, Gemma Langridge, Paul Clarke, Andrew J. Page and Mark A. Webber is published in Microbial Genomics at the following:
DOI: 10.1099/mgen.0.001106
URL: https://www.microbiologyresearch.org/content/journal/mgen/10.1099/mgen.0.001106
Funding information:
The study was funded by the Biotechnology and Biological Sciences Research Council, part of UKRI.
About the Quadram Institute
The Quadram Institute (quadram.ac.uk) is an interdisciplinary research centre at the forefront of a new era of food and health research. It brings together researchers and clinicians under one roof and houses one of Europe’s largest endoscopy units and a clinical research facility.
Based on the Norwich Research Park, The Quadram Institute is a partnership between Quadram Institute Bioscience, the Norfolk and Norwich University Hospitals NHS Foundation Trust, the University of East Anglia and the Biotechnology and Biological Sciences Research Council (BBSRC).
Its mission is to deliver healthier lives through innovation in gut health, microbiology and food and its vision is to understand how food and microbes interact to promote health and prevent disease.
About the Microbiology Society
The Microbiology Society is a membership charity for scientists interested in microbes, their effects and their practical uses. It has a worldwide membership based in universities, industry, hospitals, research institutes, schools, and other organisations. Find out more at microbiologysociety.org.
For further information please contact press@microbiologysociety.org.
Image: Quadram Institute.
